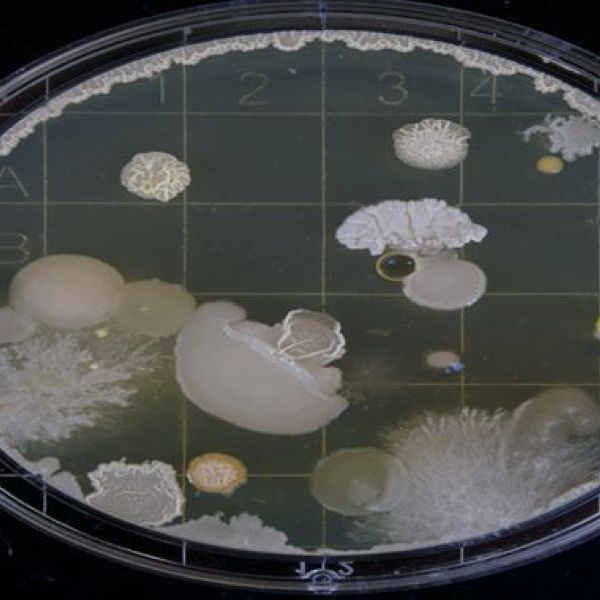

洗手液检测
政策要求
国家卫生计生委要求第一类、第二类消毒产品首次上市前需要自行或者委托第三方进行卫生安全评价,评价合格的消毒产品方可上市销售。清析研究院专业为客户提供各种洗手液检测服务,包括医用免洗洗手液检测、抗抑菌洗手液检测、普通洗手液检测等
检测范围
洗手液检测主要包括两类:
一类是传统水洗型洗手液,包括普通洗手液和抗(抑)菌洗手液;
另一类为非水洗型洗手液,即免洗洗手液(包括手消毒凝胶、速干手消毒液等),使用后无需水洗,方式有别于传统洗手液。
检测项目
洗手液类别 | 产品标准 | 检测项目 |
普通洗手液 | QB/T 2654-2013洗手液 | 铅、砷、汞、镉、菌落总数、耐热大肠菌群、铜绿假单胞菌、金黄色葡萄球菌、霉菌和酵母、总有效物、外观、气味、稳定性、pH、净含量 |
GB/T 34855-2017洗手液 | 铅、砷、汞、镉、菌落总数、耐热大肠菌群、铜绿假单胞菌、金黄色葡萄球菌、霉菌和酵母、甲醇、二噁烷、总有效物、外观、气味、稳定性、pH、净含量 | |
抗抑菌洗手液 | GB 19877.1-2005特种洗手液 | 总活性物含量、pH、甲醇、甲醛、砷、铅、汞、杀菌率/抑菌率、菌落总数 |
免洗洗手液 | GB27950-2020手消毒剂通用要求 | 有效成分含量、pH、有效期、微生物杀灭、毒理学测试、重金属 |
推荐
-

-

QQ空间
-

新浪微博
-

人人网
-

豆瓣